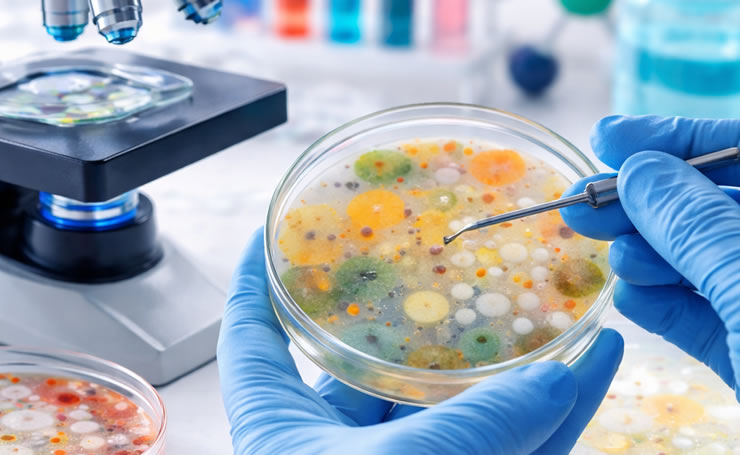
MICROBIOLOGIA

Scopri i nostri servizi specialistici

CHIMICA CLINICA
Leggi di più

EMATOLOGIA E COAGULAZIONE
Leggi di più

CHECKUP COMPLETI
Leggi di più

ESAMI TOSSICOLOGICI
Leggi di più

TEST INTOLLERANZE ALIMENTARI E ALLERGIE
Leggi di più

ESAMI FERTILITÀ
Leggi di più

DIAGNOSI PRENATALE
Leggi di più

IMMUNOMETRIA
Leggi di più

ORMONI ED ENDOCRINOLOGIA
Leggi di più

MEDICINA DEL LAVORO
Leggi di più

SERVIZI OSTETRICI
Leggi di più
MICROBIOLOGIA
Leggi di più

PERCORSI NUTRIZIONALI
Leggi di più
Gli esami del laboratorio
Orari di apertura
-
Mattino
dal lunedì al sabato
7:30 - 13:00
-
Pomeriggio
martedì e giovedì
16:30 - 18:30
-
Prelievi
dal lunedì al sabato
7:30 - 9:30